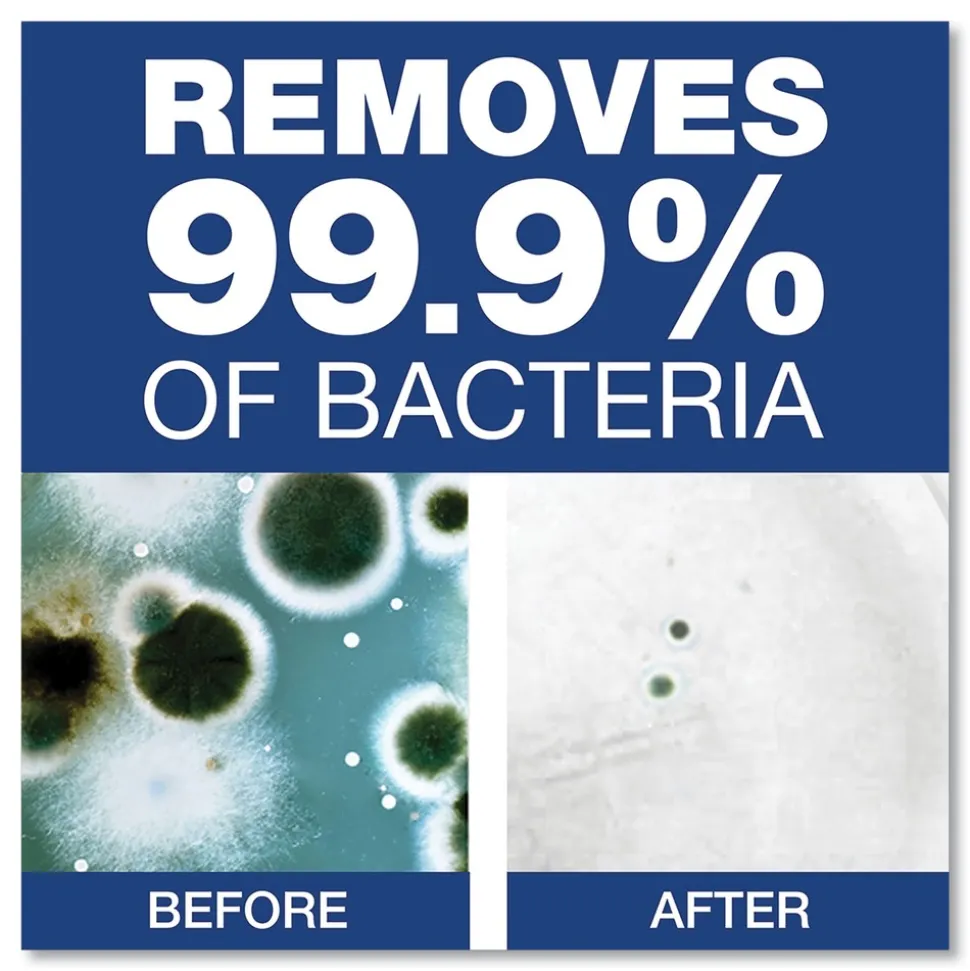
P&G Pro 1,200 mL Antibacterial E-2 Formula Foam Hand Soap Refill - Unscented (4/Carton)

P&G Pro 1,200 mL Antibacterial E-2 Formula Foam Hand Soap Refill – Unscented (4/Carton)
$59.89
Product Features & specs :
P&G Pro 47434 1,200 mL Antibacterial E-2 Formula Foam Hand Soap Refill – Unscented (4/Carton)
Details
Safeguard hand hygiene system is effective against most common bacteria, preventing infections. Contains more than 1,700 hand washes per cartridge. Mild and gentle to the skin, even after repeated use. Pleasant fragrance with no chemical odor.
Features:
-
Effective against most common bacteria
-
Helps prevent infections
-
Mild to skin, even after repeated use
-
1,200 mL sealed cartridges reduce the need to refill often and eliminates threat of contamination
-
Contains more than 1,700 hand washes per cartridge.
What’s Included:
-
(4/Carton) 1,200 mL Antibacterial E-2 Formula Foam Hand Soap Refill – Unscented – 47434
Volume Capacity
1,200 mL
Color(s)
Clear
Product Packaging
Cartridge
Soap Type
Antibacterial Foam
Scent
Unscented
Personal Soaps Application
Hand
For Use With
SafeguardT 47436, 47439
Be the first to review “P&G Pro 1,200 mL Antibacterial E-2 Formula Foam Hand Soap Refill – Unscented (4/Carton)” Cancel reply
Related products
Cleaning & Janitorial Supplies
Papernet 410112 7.9 in. x 700 ft. 1-Ply HyTech Seas Hardwound Kraft Roll Towel – Brown (6/Carton)
Cleaning & Janitorial Supplies
Safco 16 x 16.25 x 51.5 Tuff Truck 400 lb Capacity Economy Truck – Black Enamel
Cleaning & Janitorial Supplies
Cleaning & Janitorial Supplies
SPRAY n WASH 60 oz. Bottle Liquid Pre-Treat Refill (6/Carton)
Cleaning & Janitorial Supplies
Georgia Pacific Professional Angel Soft Ps 2 Ply Premium Bathroom Tissue – White (20/Carton)
Cleaning & Janitorial Supplies
Cleaning & Janitorial Supplies
Cleaning & Janitorial Supplies
Boardwalk 24 oz. Cut-End Lie-Flat Rayon Wet Mop Head – White (12/Carton)
Cleaning & Janitorial Supplies
AMREP 17 oz. Aerosol Spray Dual Action Insect Killer For Flying/Crawling Insects (12/Carton)
Cleaning & Janitorial Supplies
Boardwalk 0.94 in. Diameter x 54 in. Lacquered Hardwood Threaded End Broom Handle – Natural
Cleaning & Janitorial Supplies
2XL 6 in. x 8 in. 1-Ply Food Service No Rinse Surface Sanitizing Wipes – White (6/Carton)
Cleaning & Janitorial Supplies
Cleaning & Janitorial Supplies
Rubbermaid Commercial 36 in. Looped End Microfiber Dust Mop Head – Green
Cleaning & Janitorial Supplies
Cleaning & Janitorial Supplies
3M 3100 19 in. Diameter Ultra High-Speed Floor Burnishing Pads – Aqua (5/Carton)
Cleaning & Janitorial Supplies

Reviews
There are no reviews yet.